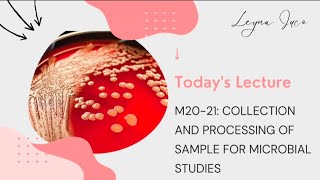

Lecture 20: Specimen Collection & Processing II video
Online izle ve mp4 mp3 formatlarinda yukle

Videonun muddeti: 36:05
Lecture 20: Specimen Collection & Processing II videosu mp4 ve mp3 yuklemek ucun hazirdir
Diqqet! Siz Mp4 yukle ve ya Mp3 yukle duymesine basdiqdan sonra eger sistem sizi reklam sehifesine atarsa o zaman derhal geri qayidib emeliyyati tekrar edin ve faylin yuklemek ucun hazir olmasini gozleyin
Videodan Mp4 Yukle
Videodan Mp3 Yukle-1
Videodan Mp3 Yukle-2
Oxshar Axtarishlar
 Lecture 20: Specimen Collection & Processing II
Lecture 20: Specimen Collection & Processing II Lecture 19: Specimen Collection & Processing I Audio
Lecture 19: Specimen Collection & Processing I Audio Specimen Collection & Processing
Specimen Collection & Processing PMLS2-M20/21: COLLECTION AND PROCESSING OF SAMPLES FOR MICROBIAL STUDIES (PART 1)
PMLS2-M20/21: COLLECTION AND PROCESSING OF SAMPLES FOR MICROBIAL STUDIES (PART 1) Phlebotomy Test Tubes (Color-Coded) - Red, Blue, Lavender, Gold, Green, Gray - Labs
Phlebotomy Test Tubes (Color-Coded) - Red, Blue, Lavender, Gold, Green, Gray - Labs Specimen collection 20-21
Specimen collection 20-21 22 6 20 2nd BSc MLT & 2nd DMLT Specimen Collection 2
22 6 20 2nd BSc MLT & 2nd DMLT Specimen Collection 2 SPECIMEN COLLECTION AND PROCESSING PART 1
SPECIMEN COLLECTION AND PROCESSING PART 1 Order of Draw and Additives | Blood Collection
Order of Draw and Additives | Blood Collection
Video Mp4 Mp3Azwap.Biz
Azwap.Biz 2021-2023


 Lecture 20: Specimen Collection & Processing II
Lecture 20: Specimen Collection & Processing II Lecture 19: Specimen Collection & Processing I Audio
Lecture 19: Specimen Collection & Processing I Audio Specimen Collection & Processing
Specimen Collection & Processing PMLS2-M20/21: COLLECTION AND PROCESSING OF SAMPLES FOR MICROBIAL STUDIES (PART 1)
PMLS2-M20/21: COLLECTION AND PROCESSING OF SAMPLES FOR MICROBIAL STUDIES (PART 1) Phlebotomy Test Tubes (Color-Coded) - Red, Blue, Lavender, Gold, Green, Gray - Labs
Phlebotomy Test Tubes (Color-Coded) - Red, Blue, Lavender, Gold, Green, Gray - Labs Specimen collection 20-21
Specimen collection 20-21 22 6 20 2nd BSc MLT & 2nd DMLT Specimen Collection 2
22 6 20 2nd BSc MLT & 2nd DMLT Specimen Collection 2 SPECIMEN COLLECTION AND PROCESSING PART 1
SPECIMEN COLLECTION AND PROCESSING PART 1 Order of Draw and Additives | Blood Collection
Order of Draw and Additives | Blood Collection